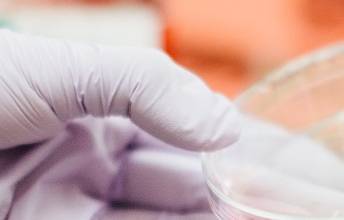

-
Мясо, выращенное в лаборатории, более критично для окружающей среды?
Потребление "заменителей мяса" является делом личного выбора, но потребитель должен быть хорошо проинформирован о свойствах и методах производства. Однако с точки зрения воздействия на окружающую среду, исходя из имеющихся на данный момент данных, производство in vitro не дает экологических преимуществ по сравнению с настоящим мясом.